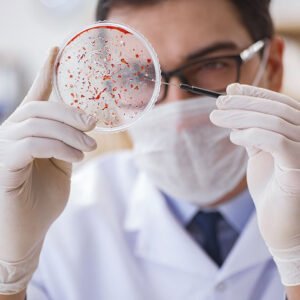
NUTRIÇÃO ESCOLAR

Agregar
Mostrando todos os 5 resultados
-
Oferta!

COACHING EDUCACIONAL
O preço original era: R$ 8.999,00.R$ 2.879,68O preço atual é: R$ 2.879,68. Adicionar ao carrinho -
Oferta!

COACHING EM ENFERMAGEM
O preço original era: R$ 8.999,00.R$ 2.879,68O preço atual é: R$ 2.879,68. Adicionar ao carrinho -
Oferta!

MBA EM GESTÃO DE ESTRATÉGIA EMPRESARIAL
O preço original era: R$ 8.464,01.R$ 2.793,12O preço atual é: R$ 2.793,12. Adicionar ao carrinho -
Oferta!

NUTRIÇÃO COM ÊNFASE EM ALIMENTAÇÃO ESCOLAR
O preço original era: R$ 8.711,35.R$ 2.787,63O preço atual é: R$ 2.787,63. Adicionar ao carrinho -
Oferta!

NUTRIÇÃO ESCOLAR
O preço original era: R$ 8.956,56.R$ 2.955,66O preço atual é: R$ 2.955,66. Adicionar ao carrinho